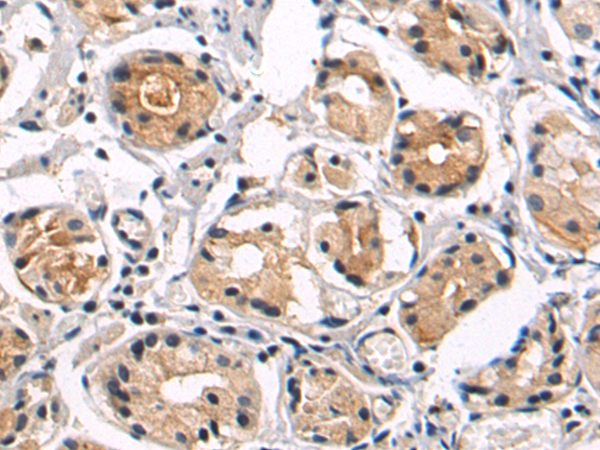
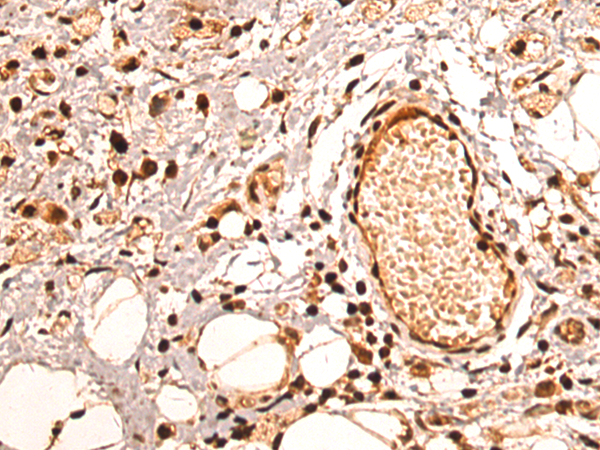

-
分类: 科研抗体货号: P04637别名:应用: IHC反应种属: Human, Mouse, Rat
-
分类: 科研抗体货号: P04732别名: NECL4; TSLL2; IGSF4C; Necl-4; synCAM4应用: WB,IHC反应种属: Human, Mouse, Rat
-
分类: 科研抗体货号: P04680别名: AM; PAMP应用: WB,IHC反应种属: Human, Mouse, Rat
-
分类: 科研抗体货号: P04748别名: p75; QA79; AIRM1; CD328; CDw328; D-siglec; SIGLEC-7; SIGLECP2; SIGLEC19P; p75/AIRM1应用: WB,IHC反应种属: Human
-
分类: 科研抗体货号: P04731别名: BI; EA2; FHM; MHP; APCA; HPCA; MHP1; SCA6; CAV2.1; CACNL1A4应用: IHC反应种属: Human
-
分类: 科研抗体货号: P04675别名: PSM; FGCP; FOLH; GCP2; PSMA; mGCP; GCPII; NAALAD1; NAALAdase应用: WB,IHC反应种属: Human
-
分类: 科研抗体货号: P04745别名: BN-1; DCR2; DRY6; CCR-6; CD196; CKRL3; GPR29; CKR-L3; CMKBR6; GPRCY4; STRL22; CC-CKR-6; C-C CKR-6应用: WB,IHC反应种属: Human
-
分类: 科研抗体货号: P04710别名: AX2R; AXIIR; C5orf39应用: WB,IHC反应种属: Human
-
分类: 科研抗体货号: P04772别名: KIF10; CENP-E; MCPH13; PPP1R61应用: WB,IHC反应种属: Human, Mouse
-
分类: 科研抗体货号: P04735别名: CANPMR应用: IHC反应种属: Human, Mouse

鄂公网安备42018502007531号
鄂公网安备42018502007531号

